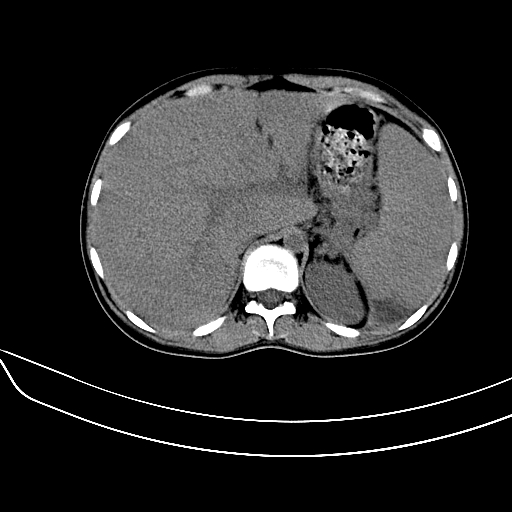

医影在线
标题: CT7307:糖尿病引起的肝、脾损害? [打印本页]
作者: 过江龙 时间: 2007-3-27 01:47
标题: CT7307:糖尿病引起的肝、脾损害?
女,22岁,临床以糖尿病等病史入院,两年前有妊娠合并胰腺炎史,现有多饮、多尿、咳嗽、咳痰、左腰痛、发热等。因多种原因没做增强。

[本贴已被 过江龙 于 2007-3-26 18:09:22 修改过]
[本贴已被 翁志蓬 于 2007-3-26 19:58:51 修改过]
作者: wqs571018 时间: 2007-3-27 01:57
图象发的太少,第二幅图肝左内叶低密度影中似有更低密度影,建议强化.
作者: jinning 时间: 2007-3-27 02:23
考虑1:肝脏肿瘤并脾脏转移;
2:左腹膜后肿瘤;
3:脾脏梗塞不排除;
4:少量腹水。
作者: 北方的狼 时间: 2007-3-27 03:30
糖尿病并发肝结核,左腹膜后冷脓肿
作者: dyqct 时间: 2007-3-27 03:49
考虑:1、不均匀性脂肪肝(肝大+不均质密度);
2、脾包膜下血肿、左侧腹膜后血肿(可能为特发性)。
作者: guzhongliangddd 时间: 2007-3-27 05:07
战友我建议患者去做mri,把平扫所见提出就行了!(很抱歉!)
作者: swyyy2007 时间: 2007-3-27 05:23
考虑:1、不均匀性脂肪肝(肝大+不均质密度);
2、脾包膜下血肿、左侧腹膜后血肿(可能为特发性)。
作者: ssmmxx 时间: 2007-3-27 05:34
考虑1: 糖尿病并发 肝脏脾脏梗塞不排除;少量腹水
作者: 悟空 时间: 2007-3-27 06:47
脾梗塞,包膜下慢性血肿。肝脏低密度病灶不好说,脂肪肝算是一种可能。
作者: 拾荒者 时间: 2007-3-27 06:49
肝、脾增大,内见多发低密度影,少量腹水,左侧肾周筋膜增厚,结合病人糖尿病史,有左腰痛、发热,考虑:糖尿病激发肝脾病变(梗塞?),左侧肾周感染,建议进一步检查。
作者: 狙击手 时间: 2007-3-27 07:08
真可惜,这么年轻就重病缠身,患者肝内,脾,肾,左下肺,左腰大肌均见病变,结合病史考虑感染可能性大。
作者: 哎呀叮叮 时间: 2007-3-27 07:29
考虑感染性病变,糖尿病最常见的并发症就是感染
作者: 汪涛同志 时间: 2007-3-27 18:23
标题: 回复:ct7307:糖尿病引起的肝、脾损害?

作者: qiuleiyu 时间: 2007-3-27 18:31
左肾周感染,腰大肌脓肿,肝脾脓肿?不能增强,就来个mri。
作者: 汪涛同志 时间: 2007-3-27 18:34
标题: 回复:ct7307:糖尿病引起的肝、脾损害?

作者: jinguoji 时间: 2007-4-2 11:22
考虑感染性病变,糖尿病最常见的并发症就是感染
| 欢迎光临 医影在线 (http://bbs.radida.com/bbs/) |
Powered by Discuz! X3.2 |